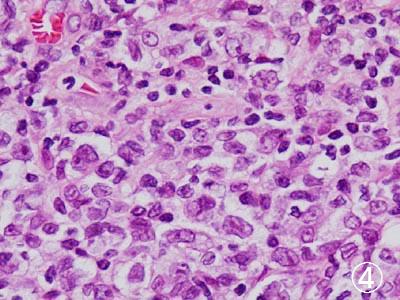
���������p��2

病理組織検査
皮膚の病変部を米粒ほど切り取り、パラフィンで固め、カンナで削るがごとく薄く切ったあと染料で染めて標本を作成し、組織の構築や細胞の姿を見て、炎症か腫瘍か、腫瘍なら良性か悪性かを診断する方法です。
痛み止めを採取部位に少量注射してから、皮膚少量をつまみとります。傷は1週で治りますが、にきび跡のような傷あとが少し残ります。検査会社に標本作成を依頼し、1週後に病理医の診断がついて返送されてきます。
病理検査が必ず必要になるのは、悪性腫瘍(がん)の診断をつける場合です。特殊な治療を要する炎症が疑われる場合にも行うことがあります。テレビや小説では「最終診断のための検査」とされ、病理医があたかも裁判官のように描かれますが、皮膚疾患の場合、現実はちょっと異なります。この検査が必要かどうかはこちらにおまかせください。
以下は病理検査結果の実例です。写真の倍率は40倍〜1000倍。


①皮膚がんの1種である有棘細胞癌。老人の顔面など長い間紫外線に曝された部位に生じることが多い。②ボーエン病。腰や太ももなどに一見汚いシミかかさぶたのような病変が生じて、拡大する場合に疑われる病変。成長して皮膚ガンになることがある。

③リンパ球のがんである悪性リンパ腫。リンパ節でなく、皮膚に生じた場合は、赤くて平らなドーム状病変のことが多く、一見虫刺されなどの炎症のようにみえて間違われることがある。④その拡大像で、皮膚に塊状に出現しているリンパ球は、炎症の場合と違って、大きくて、不揃・不整に見える。


⑤皮膚のエリテマトーデス。自分の免疫力が自分の組織を攻撃してしまう「膠原病」の1種であり、石垣のように見える皮膚の細胞層の基底部が抜けたように変性している。⑥同じ病変の深層では、特殊な染色で青く染まる粘液が、線維間に溜まっていおり、通常の皮膚炎とは全く異なる所見がみられる。


⑦皮膚結核⑧ハンセン病。ともに抗酸菌というタイプの細菌で皮膚の慢性炎症を生ずる。⑦の矢印は細菌を処理するために集まった炎症細胞が融合したもの、⑧の矢印は特殊な染色で染めた細菌本体。

⑨皮膚の中に形成された骨の組織(矢印)。顔のにきびあとなどに多発して砂粒のようにパラパラ触れる稀な疾患。